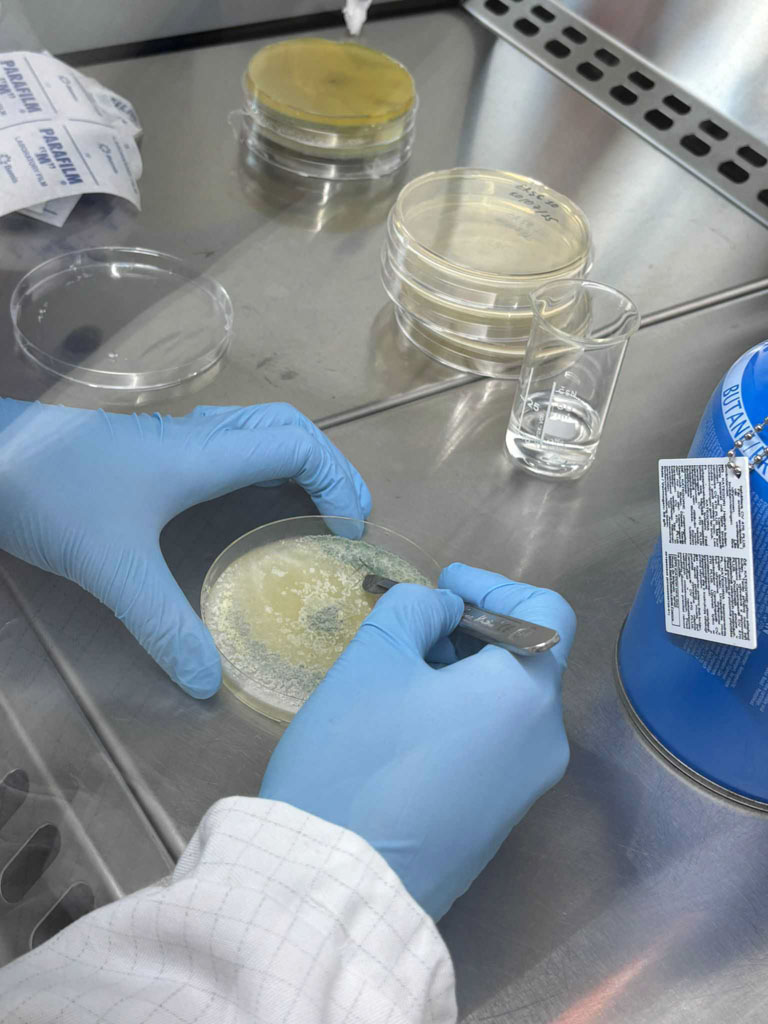

Studi & Test
Dati scientifici per decisioni concrete
Studi BPS, Studi in serra, Studi BPL, Studi su Biostimolanti e fertilizzanti, Screening di laboratorio: scopri la nostra parte opertiva.
Studi BPS
Il cuore del nostro lavoro: efficacia e selettività
Attraverso gli studi registrativi condotti in BPS (Buone Pratiche Sperimentali) si testano in campo l’efficacia contro parassiti, erbe infestanti o malattie e la selettività verso le colture. Così si ottengono dati validi da presentare nelle richieste di registrazione.
In Agrigeos gli studi di efficacia e selettività (BPS) sono il cuore dell’attività: testiamo erbicidi, fungicidi, insetticidi, nematocidi e PGR, con protocolli definiti su campo e post raccolta. Offriamo prove specifiche su shelf-life, insetti utili, resistenza al dilavamento, test triangolari e concia sementi, per risultati scientifici affidabili e su misura.
Visualizza il nostro certificato di conformità alla buona pratica per l’esecuzione delle prove di campo
Post raccolta
Prove su frutti trattati con metodo dip o drench, anche direttamente nei magazzini di lavorazione. Valutazione della shelf-life su frutta, ortaggi e prodotti di IV gamma.
Organismi non target e insetti utili
Test di selettività per verificare che i prodotti non danneggino predatori, parassitoidi e impollinatori
Studi in Serra
Gli studi in serra ci permettono di testare l’efficacia di un prodotto su colture protette, simulando la pratica agricola. Principalmente fanno parte di questa categoria le colture orticole e floricole.
Presso la nostra sede di Acate, nel cuore dell’areale produttivo siciliano, possiamo condurre prove su target critici come i nematodi, su insetti e malattie fungine. Negli ultimi anni, grazie alla rete di agricoltori con cui collaboriamo, possiamo impostare anche prove su biostimolanti e fertilizzanti.
Concia sementi
Applicazione di prodotti concianti liquidi o in polvere direttamente sui semi, per testare l’efficacia di biostimolanti, fungicidi ed insetticidi.





Altri studi
Resistenza e sensorialità
Studi sulla Resistenza e sensorialità aiutano le aziende a comprendere come si comportano i loro prodotti in alcune condizioni d’uso.
Questi studi aiutano a migliorare formulazioni e a offrire prodotti affidabili e sensorialmente coerenti.
Resistenza al dilavamento (Rain fastness)
Studi sul dilavamento dei prodotti tramite simulazione della pioggia, per valutare la resistenza all’acqua.
Test triangolari (Taint triangle test)
Prove sensoriali su frutti freschi e trasformati (come salse, vini o succhi) per rilevare eventuali alterazioni di gusto o odore seguendo la linea guida EPPO PP 1/242 (2) Taint tests
Scopri come possiamo accelerare i tuoi progetti
Studi BPL
Residui sotto controllo, secondo normativa
Con gli studi BPL (Buone Pratiche di Laboratorio) è possibile valutare i residui che un prodotto lascia su piante, frutti e processati, secondo protocolli rigorosi riconosciuti a livello europeo. Sono fondamentali per ottenere l’autorizzazione all’immissione in commercio dei prodotti fitosanitari e utili ad indicare i tempi di carenza in etichetta.
Siamo accreditati dal Ministero della Salute per condurre studi sui residui su diverse matrici. Per le aziende, questo significa avere dati certificati e validi per la registrazione.
Visualizza il nostro certificato di conformità’ ai principi della buona pratica di laboratorio
Residui su polline, nettare e miele
Fase di campo per la determinazione dei residui su polline nettare e miele (campionamenti e valutazioni condotte anche grazie ai nostri allevamenti interni di api).
Residui su prodotti trasformati
Fase di campo e di processamento per la valutazione degli effetti della lavorazione industriale e/o preparazione domestica sulla natura e sull’entità dei residui. (Analisi su olio, vino, succhi, marmellate e altri derivati, processati direttamente nel nostro laboratorio processati).
Residui su polveri
Fase di campo della raccolta delle polveri prodotte durante le attività agricole tramite teli e piastre per simulare la dispersione di polveri contaminate da prodotti fitosanitari.
DFR – Residuo Fogliare Dislocabile
Fase di campo e campionamento dei residui rimovibili dalle foglie attraverso lavaggio in soluzioni saline che simulano il sudore umano per la determinazione dei tempi di rientro in un campo dopo l’applicazione di prodotti fitosanitari.
Resistenza alla pioggia (Rain fastness)
Fase di campo di uno studio di resistenza al dilavamento di prodotti fitosanitari di copertura tramite la simulazione di eventi piovosi tramite l’utilizzo di simulatori di un simulatore di pioggia.






Studi su Biostimolanti e Fertilizzanti
Valutiamo crescita, efficienza e risposta agli stress
Gli studi su biostimolanti e fertilizzanti servono a verificare la loro efficacia, identificare le migliori condizioni d’uso e raccogliere dati utili per il loro sviluppo tecnico e commerciale.
Colture orticole
Svolgiamo prove stagionali in pieno campo e in serra per valutare crescita, resa e risposta agli stress abiotici (siccità, salinità, caldo).
Colture arboree
Agrumi, vite, olivo e drupacee sono le colture principali. Testiamo anche frutti tropicali emergenti come avocado e mango, con possibilità di prove in vaso fin dalle prime fasi di trapianto.
Colture estensive
Cereali, patata, mais, girasole, soia e barbabietola vengono seminati in clicli colturali più estesi, grazie al nostro clima favorevole. La patata, in particolare, ci consente due cicli di prova all’anno.
Ornamentali
Grazie alla collaborazione con vivai specializzati, realizziamo studi su un’ampia gamma di specie ornamentali, valutando crescita, uniformità e resistenza alle condizioni ambientali.
Servizi PLUS: cosa ci differenzia
Rilievi con drone
Un servizio integrato che offriamo per gli studi su biostimolanti. Attraverso l’analisi delle immagini aeree rileviamo parametri come NDVI, GNDVI, NDRE, LAI, GRVI e altri indici vegetativi, utili per monitorare la risposta delle colture in modo rapido e non invasivo.
PlantArray®
Una piattaforma di fenotipizzazione avanzata che misura: crescita della pianta (biomassa giornaliera); traspirazione e uso dell’acqua; conduttanza stomatica (efficienza degli scambi gassosi); contenuto idrico nel substrato; parametri ambientali come temperatura, umidità, luce e pressione.
Prove Screening
Tutto inizia qui: test rapidi e controllati
Con gli screening di laboratorio valutiamo in modo rapido e controllato l’efficacia e il comportamento delle sostanze (come principi attivi, composti repellenti/attrattivi, ecc) prima di passare a prove registrative in serra o in campo.
Sono fondamentali per selezionare le formulazioni più promettenti, identificare dosaggi ed eventuali criticità fin dalle prime fasi di sviluppo, valutare la miscibilità con altre sostanze e la modalità di applicazione.
Allevamenti di insetti
Per garantire la disponibilità costante di target specifici su cui eseguire test in condizioni controllate e fornire inoculi per le prove di efficacia assicurando una presenza omogenea del target.
Collezione patogeni
Raccolta e mantenimento di funghi e batteri fitopatogeni per prove di screening in vitro, in vivo e produzione di inoculi per le prove di efficacia.
Allevamento nematodi
Per garantirne la disponibilità costante per prove in vitro, inoculi e screening in vaso.

Metodi specifici applicati negli screening
Test di efficacia:
valutazione della sensibilità di un target ad una sostanza, preliminare ai successivi test.
Knock-down test:
misurazione della rapidità d’azione del prodotto sull’insetto target.
Semi-campo:
prove intermedie tra laboratorio e campo, in condizioni parzialmente controllate
Persistenza:
valutazione della durata dell’effetto protettivo o attivo.
Mixing test:
test di valutazione di sinergia/antagonismo tra più sostanze attive.
Test di applicazione:
individuazione del metodo applicativo più efficace (spray, drip, drench, ecc).
Test sul modo di azione e cinetica:
valutazione del comportamento di una sostanza attiva sul target (contatto, ingestione, ecc) e sulla pianta (es: sistemia).
Resistenza:
analisi della risposta del target a esposizioni ripetute per identificare fenomeni di resistenza.
Choice test:
valutazione dell’efficacia olfattiva di sostanze attrattive o repellenti mediante uso di olfattometro.
Test degradazione e dilavamento:
simulazioni per verificare la resistenza del prodotto al dilavamento da pioggia (rain tower) o alla degradazione da raggi UV (camera UV).
Hai bisogno di uno studio su misura?
Parlaci del tuo prodotto: progetteremo insieme il protocollo migliore per ottenere dati affidabili, ripetibili e utili alla registrazione o per richiedere un test specifico con insetti, patogeni o nematodi.